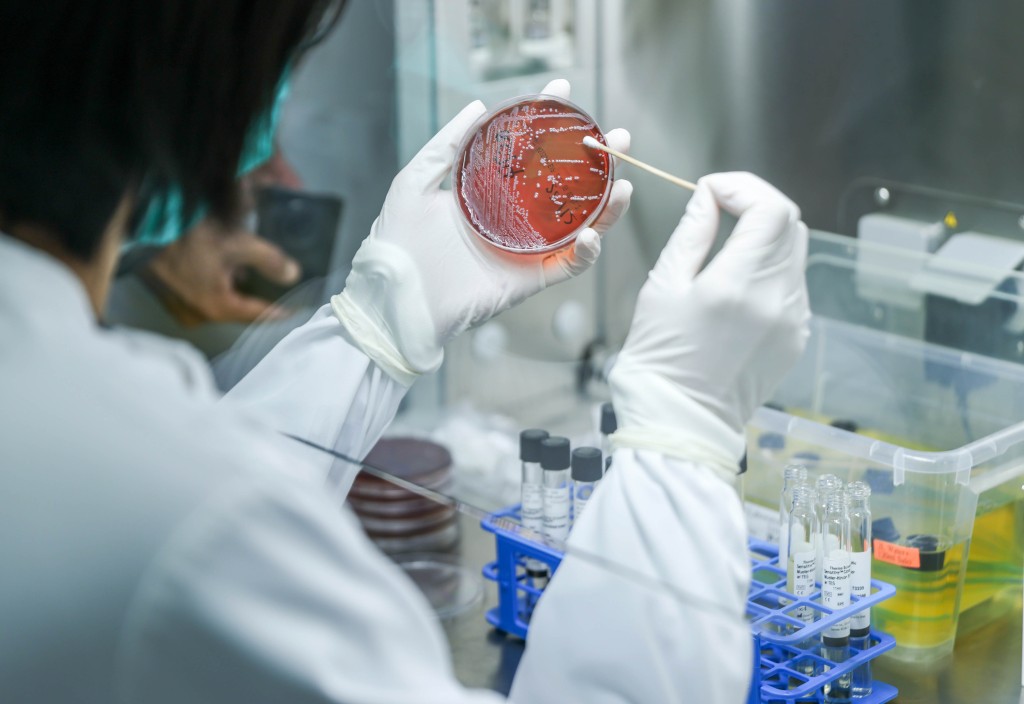
新綜合大樓的獸醫化驗科，負責檢測本地食用動物農場樣本是否有耐藥性或抗菌素。

內地貓狗檢疫期縮短 漁護署新大樓增檢疫房數量 輪候時間減半年
為防止狂犬病傳入,各地對貓狗輸入有不同檢疫要求。今年6月3日起,內地進口香港的寵物貓狗如符合規定,檢疫期由原本120天縮短至30天。漁護署表示,新動物管理及動物福利綜合大樓大幅增加檢疫設施,貓房及狗房總數量由原來16間增至40間,讓貓狗輪候檢疫時間縮短6個月。署方形容,新大樓既促進動物福利,亦節省主人的檢疫成本。
貓狗檢疫房各20間
新綜合大樓去年11月正式啟用,樓高15層,總建築面積達21,933平方米,其中7樓為動物檢疫設施,狗房及貓房各20間。狗房及貓房會每日清潔及定時消毒,貓狗會獲供應主要器具及乾糧,主人亦可自行為寵物提供床鋪或糧食。主人可親身或委託代表,於每日上午10時至中午12時,以及下午2時至4時,探望接受檢疫中的寵物。收費方面,每隻接受檢疫的狗每天收費為90元,貓每天收費為46元,從第一日去到檢疫房開始計算。

接獲300宗貓狗檢疫申請 260宗來自內地
新檢疫安排下,內地進口貓狗只需符合植入合規微型晶片、持有效狂犬病及指定傳染病防疫注射證明書等規定,來港後檢疫期可縮短至30天。漁護署獸醫師(簽證及認證)余栩慧表示,過去貓狗輪候檢疫設施時間往往超過一年,如今貓的輪候時間可以由一年半縮短至一年;狗的輪候時間由一年縮減至3到6個月,助主人節省成本。署方自去年12月起,接獲300宗貓狗檢疫申請,當中260宗來自內地;截至上周,署方發出101隻貓狗許可證,讓牠們按規定來港檢疫。
余栩慧透露,署方今年6月向愛護動物協會發出持牌檢疫中心牌照,為進口貓隻額外提供14間檢疫設施,讓貓主人有多一個選擇,並進一步降低貓隻輪候檢疫設施時間。





新綜合大樓設流浪動物暫住設施
新綜合大樓設暫住設施,讓流浪或被棄置動物暫住,其中貓房和狗房共有433間,亦設有房間讓鳥類、爬行動物等暫住。漁護署獸醫師(動物管理)關晉樂表示,這些動物情緒一般較不穩,因此會透過在貓房外放置貓咪費洛蒙,並循環播放平和的音樂等方式,舒緩動物情緒。他又稱,會安排動物訓練員訓練寵物,一旦牠們準備就緒,就會與愛護動物協會聯絡,安排領養。
另外,新綜合大樓12樓及13樓為獸醫化驗科,負責檢測本地食用動物農場樣本,包括雞的農場環境樣本及豬的排泄物。漁護署獸醫師(動物疾病)吳雪兒表示,獸醫化驗科會透過質譜儀檢查樣本內的細菌是否具有耐藥性或抗菌素,其後會呈交給動物衞生科作長期監測。
記者:曾智華
攝影:何家豪
>>>星島網WhatsApp爆料熱線(416)6775679,爆料一經錄用,薄酬致意。
>>>立即瀏覽【生活百答】欄目:新移民抵埗攻略,老華僑也未必知道的事,移民、工作、居住、食玩買、交通、報稅、銀行、福利、生育、教育。
